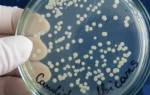

Ключевым различием между Аэробными и Анаэробными микроорганизмами является потребность в кислороде для выживания Аэробных микроорганизмов, в то время как для Анаэробных микроорганизмов он не требуется. То есть Аэробные микроорганизмы используют кислород в процессе энергетического обмена, в то время как Анаэробные микроорганизмы в нём не нуждаются.
Классификации микроорганизмов на Аэробные и Анаэробные производится на основании реакции на кислород. Из-за разницы в этой реакции Аэробные и Анаэробные микроорганизмы обладают различными характеристиками для выполнения своих функций во время клеточного дыхания. Таким образом, Аэробные микроорганизмы осуществляют аэробное дыхание, а анаэробные осуществляют анаэробное дыхание.
- Обзор и основные отличия
- Что такое Аэробные микроорганизмы
- Что такое Анаэробные микроорганизмы
- Сходство между Аэробными и Анаэробными микроорганизмами
- В чем разница между Аэробными и Анаэробными микроорганизмами
- Заключение
Аэробные микроорганизмы — это группа микроорганизмов, которые нуждаются в кислороде для своего основного выживания, роста и процесса размножения. Они окисляют моносахариды, такие как глюкоза в присутствии кислорода.

Основными процессами, генерирующими энергию в аэробах, являются гликолиз, после которого следует цикл Кребса и цепь переноса электронов. Поскольку уровень кислорода не токсичен для этих микроорганизмов, они хорошо растут в насыщенных кислородом средах. И таким образом, они являются облигатными аэробами. Примерами аэробных микроорганизмов являются Бациллы и Нокардии.
Классификация
Облигатные аэробы и микроаэрофилы являются двумя видами аэробов. Основой данной классификации является уровень токсичности кислорода для этих микроорганизмов.
- Облигатные аэробные микроорганизмы, их ещё называют аэрофилы — это микроорганизмы, которым требуется кислород для их клеточного дыхания. Кроме этого они используют кислород для окисления органических соединений, таких сахары и жиры, т.е. для получения энергии. Примером данного микроорганизма является Nocardia, Mycobacterium tuberculosis и Vibrio cholerae.
- Микроаэрофильные микроорганизмы — выживают при низких концентрациях кислорода (около 10%). Примером данного микроорганизма является бактерия Хеликобактер пилори.
Аэробные микроорганизмы это те виды бактерий, которые нуждаются в кислороде для своего основного выживания, роста и процесса размножения. Очень легко выделить эти бактерии путем культивирования массы бактериальных штаммов в некоторой жидкой среде. Поскольку они нуждаются в кислороде для выживания, они, как правило, выходят на поверхность в попытке получить максимум доступного кислорода.

Классификация
К анаэробным микроорганизмам относятся факультативные анаэробы, аэротолерантные анаэробы и облигатные анаэробы. Основой данной классификации, также и у аэробов, является уровень токсичности кислорода для этих микроорганизмов.
- Аэротолерантные анаэробы — им не требуется кислород для выживания. Присутствие кислорода не вредит этим микроорганизмам. Примером данного микроорганизма является бактерии Лактобациллы.
- Облигатные анаэробы — это микроорганизмы, которые живут и растут только при отсутствии кислорода в окружающей среде, так как он губителен для них. Примером данного микроорганизма является Клостридии (Clostridium butyricum) и Метаносарцины (Methanosarcina barkeri).
- Факультативныеанаэробы — эти микробы могут выживать как в присутствии, так и в отсутствии кислорода. Примером данного микроорганизма является бактероид Кишечная палочка.
Анаэробные микроорганизмы не выживают в богатой кислородом окружающей среде, так как кислород токсичен для облигатных анаэробов. Напротив, избыток кислорода не вредит факультативным анаэробам.
- По своей природе как аэробные, так и анаэробные микроорганизмы являются прокариотическими.
- Оба этих микроба подвергаются гликолизу, который является первой стадией клеточного дыхания.
- Аэробные и анаэробные состоят из патогенных болезнетворных микроорганизмов.
- Оба типа микробов используются в различных сферах промышленности.
| Аэробные микроорганизмы — это организмы, которым для выживания необходим кислород, поскольку он является конечным акцептором электронов в их клеточном дыхании | Анаэробные микроорганизмы — это микробы, которым не требуется кислород для клеточного дыхания |
| Кислород является конечным акцептором электронов аэробных микроорганизмов | Сера, Азот, Метан, Железо являются конечными акцепторами электронов анаэробных микроорганизмов |
| Гликолиз, цикл Кребса и цепь переноса электронов — три стадии клеточного дыхания | Гликолиз и ферментация являются стадиями анаэробного дыхания |
| Облигатный, факультативный, аэротолерантный и микроаэрофильный | Облигатные и факультативные анаэробы |
| Облигационные аэробы требуют богатых кислородом сред | Облигатные анаэробы требуют сред, лишенных кислорода |
| Для аэробов кислород нетоксичен | Анаэробные микроорганизмы очень токсичны для кислорода |
| Присутствует в аэробах | Отсутствует в анаэробах |
| Производство энергии высоко в аэробах | Производство энергии в анаэробах низкое |
| Сенная палочка (Bacillus spp), Синегнойная палочка (Pseudomonas aeruginosa), Палочка Коха (Mycobacterium tuberculosis) | Актиномицеты (Actinomyces), Бактероиды (Bacteroides), Пропионовокислые бактерии (Propionibacterium), Вейлонелла (Veillonella), Пептострептококки (Peptostreptococcus), Порфиромонас (Porphyromonas), Клостридии (Clostridium spp) |
Аэробные и Анаэробные микроорганизмы различаются в потребности кислородом для выживания. Аэробные микроорганизмы используют кислород в процессе энергетического обмена, в то время как Анаэробные бактерии его не используют. Анаэробы используют для энергетического обмена такие вещества, как нитраты, сера и метан. Поэтому ключевым различием между Аэробными и Анаэробными микроорганизмами является тип конечного акцептора электронов, который они используют при клеточном дыхании.
I
Анаэробы (греч. отрицательная приставка an- + aēr воздух + b [ios] жизнь)
микроорганизмы, развивающиеся при отсутствии в окружающей их среде свободного кислорода. Обнаруживаются практически во всех образцах патологического материала при различных гнойно-воспалительных заболеваниях, являются условно-патогенными, иногда патогенными. Различают факультативные и облигатные А. Факультативные А. способны существовать и размножаться как в кислородной, так и в бескислородной среде. К ним относятся кишечная палочка, иерсинии, стафилококки, стрептококки, шигеллы и другие Бактерии.
Облигатные А. погибают при наличии свободного кислорода в окружающей среде. Их разделяют на две группы: бактерии, образующие споры, или клостридии, и бактерии, не образующие спор, или так называемые неклостридиальные анаэробы. Среди клостридий различают возбудителей анаэробных клостридиальных инфекций — ботулизма, клостридиальной раневой инфекции, столбняка. К неклостридиальным А. относят грамотрицательные и грамположительные бактерии палочковидной или шаровидной формы: бактероиды, фузобактерии, вейллонеллы, пептококки, пептострептококки, пропионибактерии, эубактерии и др. Неклостридиальные А. являются составной частью нормальной микрофлоры человека и животных, но в то же время играют большую роль в развитии таких гнойно-воспалительных процессов, как перитонит, абсцессы легких и головного мозга, пневмония, эмпиема плевры, флегмоны челюстно-лицевой области, сепсис, отит и др. Большинство анаэробных инфекций (Анаэробная инфекция), вызываемых неклостридиальными анаэробами, относится к эндогенным и развивается главным образом при снижении резистентности организма в результате травмы, оперативного вмешательства, охлаждения, нарушения иммунитета.
Основную часть клинически значимых А. составляют бактероиды и фузобактерии, пептострептококки и споровые грамположительные палочки. На долю бактероидов приходится около половины гнойно-воспалительных процессов, вызванных анаэробными бактериями.
Бактероиды (Bacteroides) — род грамотрицательных облигатных анаэробных бактерий семейства Bacteroidaceae, палочки с биполярной окрашиваемостью, размером 0,5—1,5×1—15 мкм, неподвижные или движущиеся с помощью перитрихиально расположенных жгутиков, нередко имеют полисахаридную капсулу, являющуюся фактором вирулентности. Продуцируют различные токсины и ферменты, действующие в качестве факторов вирулентности. По чувствительности к антибиотикам неоднородны: бактероиды, например группы В. fragilis, устойчивы к бензилпенициллину. Устойчивые к β-лактамным антибиотикам бактероиды продуцируют β-лактамазы (пенициллиназы и цефалоспориназы), разрушающие пенициллин и цефалоспорины. Бактероиды чувствительны к некоторым производным имидазола — метронидазолу (трихополу, флагилу), тинидазолу, орнидазолу — препаратам, эффективным против различных групп анаэробных бактерий, а также к левомицетину и эритромицину. Бактероиды устойчивы к аминогликозидам — гентамицину, канамицину, стрептомицину, полимиксину, олеандомицину. Значительная часть бактероидов устойчива к тетрациклинам.
Фузобактерии (Fusobacterium) — род грамотрицательных палочковидных облигатных анаэробных бактерий; обитают на слизистой оболочке рта и кишечника, бывают неподвижными или подвижными, содержат мощный эндотоксин. Наиболее часто в патологическом материале обнаруживают F. nucleatum и F. necrophorum. Большинство фузобактерии чувствительны к β-лактамным антибиотикам, однако встречаются резистентные к пенициллину штаммы. Фузобактерии, за исключением F. varium, чувствительны к клиндамицину.
Пептострептококки (Peptostreptococcus) — род грамположительных сферических бактерий; располагаются парами, тетрадами, в виде неправильных скоплений или цепочек. Жгутиков не имеют, спор не образуют. Чувствительны к пенициллину, карбенициллину, цефалоспоринам, хлорамфениколу, устойчивы к метронидазолу.
Пептококки (Peptococcus) — род грамположительных сферических бактерий, представленный единственным видом P. niger. Располагаются поодиночке, парами, иногда в виде скоплений. Жгутиков и спор не образуют. Чувствительны к пенициллину, карбенициллину, эритромицину, клиндамицину, хлорамфениколу. Относительно устойчивы к метронидазолу.
Вейонеллы (Veillonella) — род грамотрицательных анаэробных диплококков; располагаются в виде коротких цепочек, неподвижны, спор не образуют. Чувствительны к пенициллину, левомицетину, тетрациклину, полимиксину, эритромицину, резистентны к стрептомицину, неомицину, ванкомицину.
Из других неклостридиальных анаэробных бактерий, выделяющихся из патологического материала больных, следует упомянуть грамположительные пропионовые бактерии, грамотрицательные волинеллы и другие, значение которых менее изучено.
Клостридий (Clostridium) — род грамположительных палочковидных спорообразующих анаэробных бактерий. Клостридий широко распространены в природе, особенно в почве, обитают также в желудочно-кишечном тракте человека и животных. Около десяти видов клостридий являются патогенными для человека и животных: С. perfringens, С. novyii, С. septicum, С. ramosum, С. botulirnim, С. tetani, С. difficile и др. Эти бактерии образуют специфические для каждого вида экзотоксины высокой биологической активности, к которым чувствительны человек и многие виды животных. С. difficile — подвижные, имеющие перитрихиально расположенные жгутики, бактерии. По мнению ряда исследователей, эти бактерии после нерациональной антимикробной терапии, размножившись, могут вызывать псевдомембранозный колит. С. difficile чувствительны к пенициллину, ампициллину, ванкомицину, рифампицину, метронидазолу; устойчивы к аминогликозидам.
Возбудителем анаэробной инфекции может быть какой-либо один вид бактерий, однако чаще эти инфекции вызываются различными ассоциациями микробов: анаэробно-анаэробной (бактероиды и фузобактерии); анаэробно-аэробной (бактероиды и стафилококки, клостридий и стафилококки) и т.д.
Для выделения облигатных А. требуются специальное оборудование и Питательные среды. Применяются также различные методы культивирования анаэробов, сущность которых сводится к удалению кислорода из среды (культивирование в анаэростате, посев уколом в высокий столбик питательного агара, добавление в питательную среду веществ, восстанавливающих кислород, например пирогаллола). Биологический метод создания бескислородных условий для А. заключается в совместном культивировании аэробных и анаэробных культур. Для проведения бактериологического анализа на облигатные А. необходимо правильно забирать и транспортировать патологический материал. Так, после пункции его следует доставлять в шприце или в специальных транспортных средах. Доставка материала на обычных тампонах малоэффективна. Идентификация А. принципиально не отличается от идентификации аэробов (см. Микробиологическая диагностика).
Библиогр.: Лабораторные методы исследования в клинике, под ред. В.В. Меньшикова. М., 1987.
II
Анаэробы (Ан- + Аэробы, син. микроорганизмы анаэробные)
1) в бактериологии — микроорганизмы, способные существовать и размножаться при отсутствии в окружающей среде свободного кислорода;
2) в биологии — см. Организм анаэробный.
Анаэробы облигатные — А., погибающие при наличии свободного кислорода в окружающей среде.
Анаэробы факультативные — А., способные существовать и размножаться как при отсутствии, так и при наличии свободного кислорода в окружающей среде.
Последнее обновление — 25 января 2018 в 15:59
Время на чтение: 5 мин
Бактерии присутствуют везде, их количество огромное, виды разные. Анаэробные бактерии – те же виды микроорганизмов. Могут развиваться и жить независимо, есть ли кислород в средах их питания или его не существует совсем.
Энергию анаэробные бактерии получают при субстратном фосфорилировании. Существуют аэробы факультативного вида, облигатного или других разновидностей анаэробных бактерий.
Перечень инфекций вызванных анаэробными бактериями

Факультативные виды бактерий есть почти везде. Причина их существования – изменение одного метаболического пути на совершенно другой. К этому виду относят кишечную палочку, стафилококки, шигеллу, прочие. Это опасные анаэробные бактерии.
Если отсутствует свободный кислород, то облигатные бактерии гибнут.
Располагаются по классам:
- Клостридии – облигатные типы аэробных бактерий, могут образовывать споры. Это возбудители ботулизма или столбняка.
- Неклостридиальные анаэробные бактерии. Разновидности из микрофлоры живых организмов. Играют существенную роль при образовании разных гнойных заболеваниях и воспалительных. Неспорообразующие типы бактерий живут в полости рта, в ЖКТ. На кожных покровах, в половых органах женщин.
- Капнеистические анаэробы. Живут при преувеличенном скоплении углекислоты.
- Аэротолерантные бактерии. При наличии молекулярного кислорода этот тип микроорганизмов никого дыхания не имеет. Но и не погибает.
- Умеренно-строгие типы анаэробов. В среде с кислородом не погибают, не размножаются. Бактерии этого вида для жизни требуют среду питания со сниженным давлением.
Анаэробы – бактероиды

Считаются более важными аэробными бактериями. Составляют 50% от всех воспалительных и гнойных видов. Возбудителями их являются анаэробы бактерии или бактероиды. Это граммотрицательные облигатные типы бактерий.
Палочки с биполярной окрашиваемостью и размерами от 0,5 и до 1,5, на площадях примерно в 15 мкм. Могут производить выработку ферментов, токсинов, вызвать вирулентность. Зависят по устойчивости от антибиотиков. Могут быть устойчивыми, или просто чувствительными. Все анаэробные микроорганизмы очень устойчивые.
Образование энергии для грамотрицательных облигатных анаэробов осуществляется в человеческих тканях. Некоторые из тканей организмов имеют увеличенную устойчивость к уменьшенному значению кислорода в среде питания.
В условиях стандарта синтез аденозинтрифосфата выполняется только аэробным способом. Это происходит при увеличенных физических усилиях, воспалениях, где действуют анаэробы.
АТФ – это аденозинтрифосфат или кислота, которая появляется во время образования энергии в организме. Есть несколько вариаций синтеза данного вещества. Один из них аэробный, или составляет три вариации анаэробов.
Анаэробные механизмы для синтеза аденозинтрифосфата:
- перефосфорилирование, которое осуществляется между аденозинтрифосфатом и креатинфосфатом;
- образование трансфосфорилирования молекул аденозинтрифосфата;
- анаэробное расщепление составляющих крови глюкозы, гликогена.
Образование анаэробов

Предназначение микробиологов – культивирование бактерий анаэробов. Чтобы это осуществлять требуется специализированная микрофлора, и концентрация метаболитов. Применяют его обычно при исследованиях разного характера.
К примеру, при обнаружении паразитов, которые живут в каждом человеке. Именно паразиты могут вызывать разные виды заболеваний.
Есть специальные методы по взращиванию анаэробов. Происходят при замене воздуха на смеси газов. Происходит действие в термостатах с герметизацией. Так растут анаэробы. Другой метод – взращивание микроорганизмов с добавкой редуцирующих средств.
Сфера питания
Есть сфера питания с общим видом или дифференциально-диагностическим. Базовой – для вида Вильсона-Блера служит агар-агар, имеющий среди составляющих некоторое содержание глюкозы, 2-х хлористого железа, натриевый сульфит. Есть среди них колонии, которые называют черными.
Сферу Ресселя применяют при исследовании биохимических качеств бактерий с названием сальмонеллы или шигеллы. Эта среда может в составе иметь и глюкозу, и агар-агар.
Среда Плоскирева такая, что может сдерживать рост некоторых микроорганизмов. Они составляют множество. По этой причине ее применяют для возможности дифференциально-диагностической. Здесь могут с успехом вырабатываться дизентерийные возбудители, брюшного тифа, прочие болезнетворные анаэробы.
Главное направление среды агаров висмут-сульфитных – этот метод предназначен выделение сальмонелл. Это выполняется при умении сальмонелл вырабатывать сероводород.
В организме каждой живой особи, живет множество анаэробов. Они вызывают у них разнообразные виды инфекционных заболеваний. Заражение инфекцией может происходить лишь при ослабленном иммунитете или срывах микрофлоры. Есть вероятность попадания инфекций в живой организм из среды обитания. Это может быть осенью, в зимний период. Такое попадание инфекций сохраняется на протяжении перечисленных периодов. Вызываемый недуг иногда дает осложнения.
Инфекции, вызванные микроорганизмами – анаэробными бактериями, напрямую увязаны с флорой слизистых оболочек живых особей. С проживанием мест анаэробов. У каждой инфекции существует несколько возбудителей. Их количество доходит обычно до десяти. Абсолютно уточненное количество заболеваний, вызывающий анаэроб, с точностью определить нельзя.
Из-за трудного отбора материалов, предназначенных для изучения перевозки образцов, определения бактерий. Поэтому данный вид составляющих зачастую обнаруживается только при уже хронических воспалениях у человека. Это пример невнимательного отношения к своему здоровью.
Анаэробным инфекциям периодически подвергаются абсолютно все люди с разными возрастами. У малых детей степень инфекционных воспалений намного больше, чем у людей другого возраста. Анаэробы зачастую вызывают у человека заболевания внутри черепа. Абсцессы, менингиты, прочие виды заболеваний. Распространение анаэробов выполняется с током крови.
Если у человека заболевание хроническое, то анаэробы могут образовывать аномалии в области шеи или головы. Например: абсцессы, отит или лимфадениты. Бактерии опасны для ЖКТ, легких пациентов.
Если у женщины существуют болезни мочеполовой системы, то появляется риск возникновения анаэробных инфекций. Разные болезни кожи, суставов – это тоже следствие жизни анаэробов. Этот способ один из первых говорит о наличии инфекции.
Причины для появления инфекционных заболеваний
К появлению инфекций человека приводят те процессы, при которых на его организм попадают энергичные бактерии-анаэробы. Развитию болезни может сопутствовать неустойчивое кровоснабжение, появление некроза тканей. Это могут травмы разного характера, отечность, опухоли, нарушения сосудов. Появление инфекций в полости рта, заболевания в легких, воспаление тазовых органов, прочие болезни.
Инфекция может развиваться своеобразно для каждого вида. На развитие влияет тип возбудителя инфекции, здоровье пациента. Диагностировать такие инфекции затруднительно. Серьезность диагностов зачастую основана лишь на одних предположениях. Существует отличие особенностей инфекций, которые возникают от неклостридиальных анаэробов.
Первейшие признаки при заражениях – это газообразование, какие-либо нагноения, появления тромбофлебита. Иногда в качестве признаков могут быть опухоли или новообразования. Они могут быть новообразованиями ЖКТ, маточными. Сопровождаются формированием анаэробов. В это время от человека может исходить неприятный запах. Но, даже если запаха не существует, это не означает, что анаэробов, как возбудителей для инфекции, в данном организме нет.
Особенности для получения образцов
Первейшее исследование при инфекциях, вызванных анаэробами – это внешний осмотр общего вида человека, его кожных покровов. Потому что наличие кожных заболеваний у человека – это осложнения. Они свидетельствуют, что о жизнедеятельности бактерий наличием газов в зараженных тканях.
При лабораторных исследованиях, определения уточненного диагноза, необходимо правильно заполучить образец зараженной материи. Зачастую применяют специализированную технику. Самым лучшим методом получения образцов считается аспирация, выполненная с помощь прямой иглы.
Получение материалов способом мазков не рекомендуют. Иногда этот способ получения мазка все-таки допускается.
Виды проб, несоответствующие возможности продолжения анализов:
- мокрота, приобретенная самовыделением;
- пробы бронхоскопии;
- виды мазков от сводов влагалища;
- моча от свободного мочеиспускания;
- виды фекалий.
Исследованиям подлежат пробы:
- крови;
- жидкости плевральной;
- транстрахеальных аспиратов;
- гноя, взятого из абсцессов
- жидкости из мозга спины;
- пунктатов легких.
Образцы перемещать по месту назначения надо оперативно. Выполняется работа в специализированном контейнере, иногда в сумке из пластмассы.
Она должна быть предназначена к анаэробным условиям. Потому что взаимодействие образцов с кислородом воздуха, может вызывать полную гибель бактерий. Жидкие виды образцов перемещают в пробирках, иногда прямо в шприцах.
Если для исследований перемещают тампоны, то их перевозят только в пробирках с наличием углекислых газов, иногда с предварительно изготовленными веществами.
Практически все живые организмы на Земле нуждаются в процессе дыхания. Кислород является одним из наиболее распространенных окислителей в дыхательной цепи животных, растений, протистов, многих бактерий. Однако не всем известно, насколько наш организм отличается по сложности строения от маленьких клеток микроорганизмов. Возникает вопрос: как дышат бактерии? Отличается ли их способ получения энергии от нашего?
Все ли бактерии дышат кислородом?
Не все знают, что кислород не всегда является обязательным компонентом в цепи дыхания. Он играет, прежде всего, роль акцептора электронов, поэтому данный газ хорошо окисляется и взаимодействует с протонами водорода. АТФ – это та причина, по которой все живые организмы дышат. Однако многие виды бактерий обходятся без кислорода, и все равно получают такой заветный источник энергии, как аденозинтрифосфат. Как дышат бактерии такого типа?
Процесс дыхания в нашем организме протекает на протяжении двух стадий. Первая из них – анаэробная – не требует наличия кислорода в клетке, и для нее необходимы только источники углерода и акцепторы протонов водорода. Вторая стадия – аэробная – протекает исключительно в присутствии кислорода и характеризуется большим количеством поэтапных реакций.
У бактерий, которые не усваивают кислород и не используют его для дыхания, протекает только анаэробная стадия. По ее окончанию микроорганизмы также получают АТФ, однако его количество очень сильно отличается от того, которое получаем мы после прохождения сразу двух стадий дыхания. Получается, что не все бактерии дышат кислородом.
АТФ – универсальный источник энергии
Для любого организма важно поддерживать свою жизнедеятельность. Поэтому нужно было в процессе эволюции найти источники энергии, которые при использовании смогут дать достаточно ресурсов для протекания всех необходимых реакций в клетке. Сначала появилось брожение у бактерий: так называется этап гликолиза или анаэробный этап дыхания прокариот. И только потом у более совершенных многоклеточных организмов развились приспособления, благодаря которым, с участием атмосферного кислорода КПД дыхания заметно увеличивалось. Так появился аэробный этап клеточного дыхания.
Как дышат бактерии? 6 класс школьного курса биологии показывает, что для любого организма важно получение определенной доли энергии. В процессе эволюции она стала запасаться в специально синтезированных для этого молекулах, которые называются аденозинтрифосфат.
АТФ представляет собой макроэргическое вещество, основой которого является пентозное углеродное кольцо, азотистое основание (аденозин). От него отходят фосфорные остатки, между которыми и образуются высокоэнергетические связи. При разрушении одной из них высвобождается в среднем около 40 кДж, а одна молекула АТФ способна хранить в себе максимум три фосфорных остатка. Так, если АТФ распадается до АДФ (аденозиддифосфат), то клетка получает 40 кДж энергии в процессе дефосфорилирования. И, наоборот, запасание происходит путем фосфорилирования АДФ до АТФ с затратой энергии.
Как дышат бактерии? Типы дыхания
По отношению к кислороду все прокариоты делятся на несколько групп. Среди них:
- Облигатные анаэробы.
- Факультативные анаэробы.
- Облигатные аэробы.
Первая группа состоит только из тех бактерий, которые не могут жить в условиях доступа кислорода. О2 для них токсичен и ведет к гибели клетки. Примерами таких бактерий могут служить чисто симбиотические прокариоты, которые проживают внутри другого организма в условиях отсутствия кислорода.
Вторая группа объединяет такие виды прокариот, которые активно размножаются и растут при отсутствии кислорода, однако, его небольшое процентное содержание в окружающей среде не ведет к летальным последствиям. К таким бактериям относятся сапрофиты и некоторые паразиты.
Как дышат бактерии третьей группы? Эти прокариоты отличаются тем, что они могут жить только в условиях хорошей аэролизации. Если недостаточно кислорода в воздухе, такие клетки быстро погибают, поскольку для дыхания им жизненно необходим О2.
Чем брожение отличается от кислородного дыхания?
Брожение у бактерий – это тот же самый процесс гликолиза, который у разных видов прокариот может давать различные продукты реакции. Например, молочнокислое брожение приводит к образованию побочного продукта молочной кислоты, спиртовое брожение – этанола и углекислого газа, масляно-кислое – масляной (бутановой) кислоты и т. д.
Кислородное дыхание – это полная цепь процессов, которые начинаются с этапа гликолиза с образованием пировиноградной кислоты, и заканчиваются выделением СО2, Н2О и энергии. Последние реакции проходят в условиях присутствия кислорода.
Как дышат бактерии? Биология (6 класс) школьного курса микробиологии
В школе нам давали лишь простейшие знания о том, как происходит процесс дыхания прокариот. Митохондрий у этих микроорганизмов нет, однако, есть мезосомы – выпячивания цитоплазматической мембраны внутрь клетки. Но эти структуры играют не самую ключевую роль в дыхании бактерий.
Поскольку брожение – это разновидность гликолиза, то оно протекает в цитоплазме прокариот. Там же находятся многочисленные ферменты, необходимые для проведения всей цепочки реакций. У всех бактерий без исключения сначала образуются две молекулы пировиноградной кислоты, как у человека. И только потом они превращаются в другие побочные продукты, которые зависят от типа брожения.
Заключение
Мир прокариот, несмотря на видимую простоту клеточной организации, полон сложных и порой необъяснимых моментов. Теперь есть ответ, как дышат бактерии на самом деле, ведь не всем из них необходим кислород. Напротив, большинство приспособилось использовать другой, менее практичный способ получения энергии – брожение.
Читайте также: